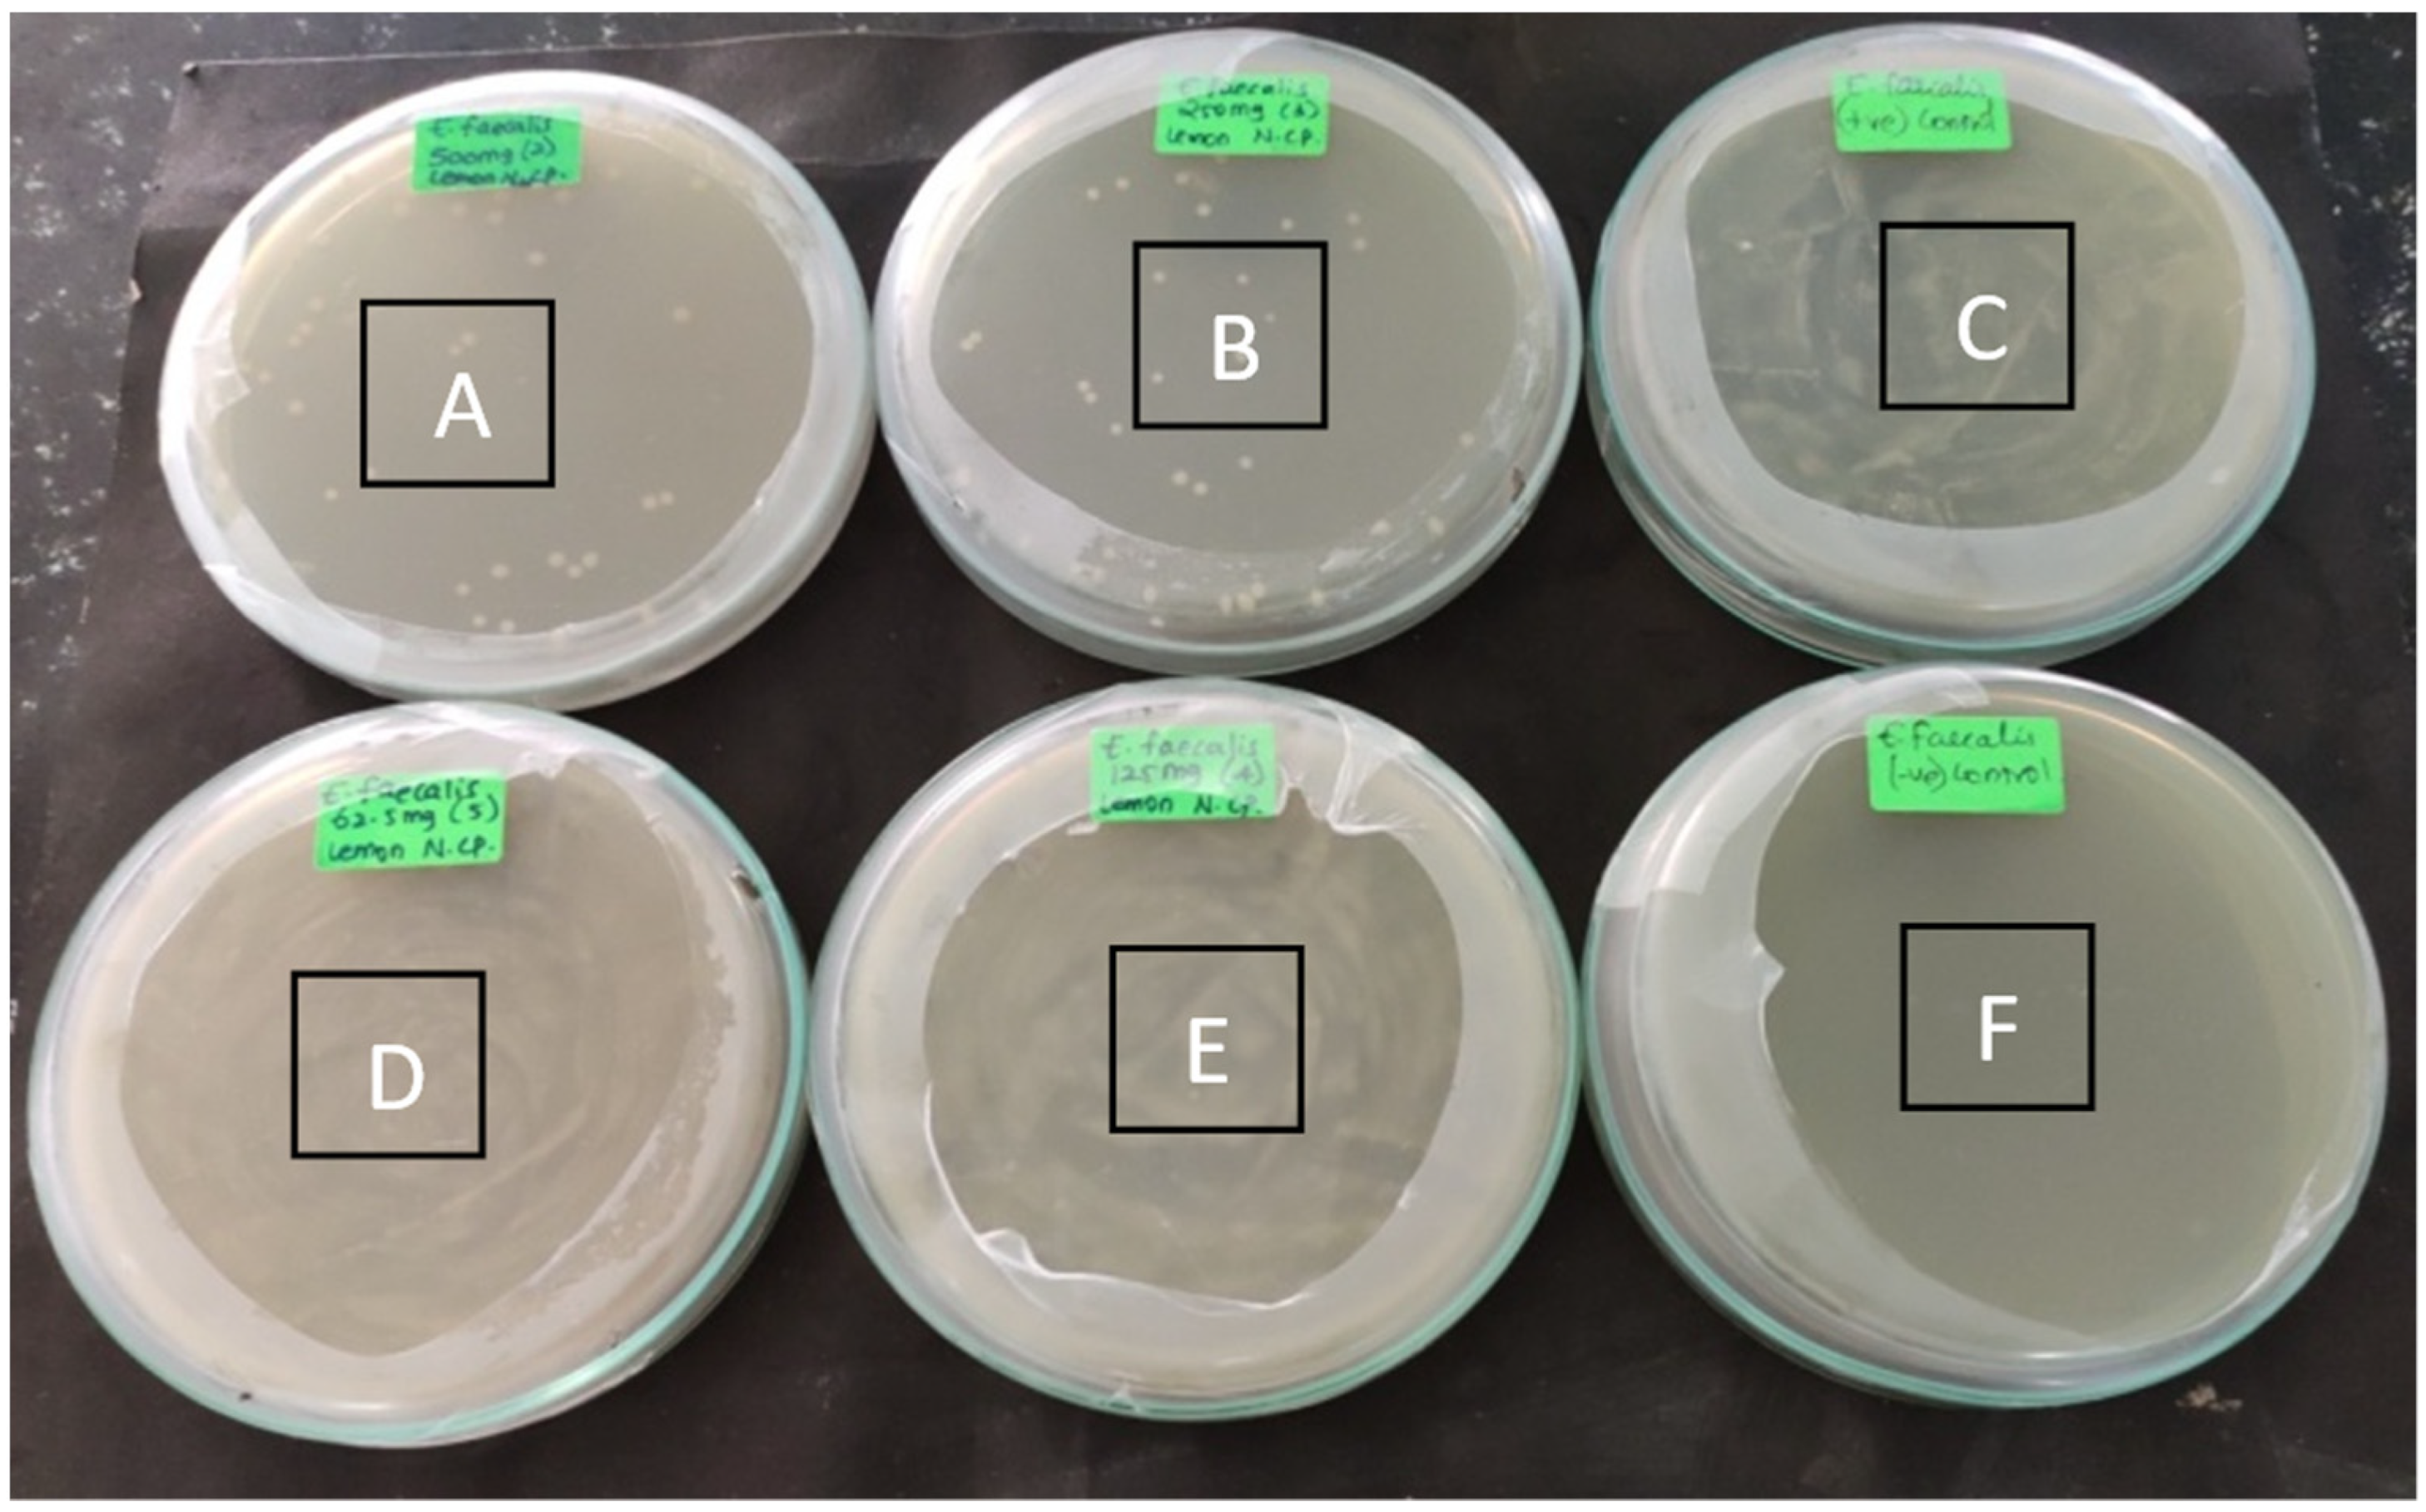

Preparation of a Novel Nanocomposite and Its Antibacterial Effectiveness against Enterococcus faecalis—An In Vitro Evaluation
Abstract
:1. Introduction
2. Materials and Methods
2.1. Characteristics of This Study
2.2. Materials
2.3. Synthesis of the Various NPs
2.3.1. Synthesis of Lemon Extract Mediated Zinc NP (Li-ZnNP)
2.3.2. Synthesis of Lemon Extract-Mediated Silver NP (Li-Ag NP)
2.3.3. Synthesis of Lemon Extract-Mediated Chitosan NP (Li-CSNP)
2.4. Synthesis of Lemon Extract-Mediated Silver/Zinc/Chitosan-Based Nanocomposite (Li-Ag/Zn/CS NC)
2.5. Characterization of the Various Nanoparticles (NPs)
2.6. Antimicrobial Activity of the Different Nanoparticles against Enterococcus faecalis
2.7. Time-Kill Assay
2.8. Statistical Analysis
3. Results
3.1. Characterization of the Nanoparticles (NPs)
3.2. Antimicrobial Susceptibility
3.3. Antibacterial Activity
3.4. Time-Kill Assay
4. Discussion
5. Strength Limitations and Future Directions
6. Conclusions
Author Contributions
Funding
Institutional Review Board Statement
Informed Consent Statement
Data Availability Statement
Conflicts of Interest
References
- Murthy, S.K. Nanoparticles in Modern Medicine: State of the Art and Future Challenges. Int. J. Nanomed. 2007, 2, 129–141. [Google Scholar]
- Raliya, R.; Chadha, T.S.; Hadad, K.; Biswas, P. Perspective on Nanoparticle Technology for Biomedical Use. Curr. Pharm. Des. 2016, 22, 2481–2490. [Google Scholar] [CrossRef] [PubMed] [Green Version]
- Díez-Pascual, A. Antibacterial Activity of Nanomaterials. Nanomaterials 2018, 8, 359. [Google Scholar] [CrossRef] [PubMed] [Green Version]
- Ferrando-Magraner, E.; Bellot-Arcís, C.; Paredes-Gallardo, V.; Almerich-Silla, J.M.; García-Sanz, V.; Fernández-Alonso, M.; Montiel-Company, J.M. Antibacterial Properties of Nanoparticles in Dental Restorative Materials. A Systematic Review and Meta-Analysis. Medicina 2020, 56, 55. [Google Scholar] [CrossRef] [Green Version]
- Melo, M.A.S.; Cheng, L.; Weir, M.D.; Hsia, R.-C.; Rodrigues, L.K.A.; Xu, H.H.K. Novel Dental Adhesive Containing Antibacterial Agents and Calcium Phosphate Nanoparticles. J. Biomed. Mater. Res. B Appl. Biomater. 2013, 101B, 620–629. [Google Scholar] [CrossRef] [Green Version]
- Melo, M.A.S.; Cheng, L.; Zhang, K.; Weir, M.D.; Rodrigues, L.K.A.; Xu, H.H.K. Novel Dental Adhesives Containing Nanoparticles of Silver and Amorphous Calcium Phosphate. Dent. Mater. 2013, 29, 199–210. [Google Scholar] [CrossRef] [Green Version]
- Yu, B.; Ahn, J.-S.; Lim, J.I.; Lee, Y.-K. Influence of TiO2 Nanoparticles on the Optical Properties of Resin Composites. Dent. Mater. 2009, 25, 1142–1147. [Google Scholar] [CrossRef]
- Love, R.M. Enterococcus Faecalis—A Mechanism for Its Role in Endodontic Failure. Int. Endod. J. 2001, 34, 399–405. [Google Scholar] [CrossRef]
- Stuart, C.; Schwartz, S.; Beeson, T.; Owatz, C. Enterococcus Faecalis: Its Role in Root Canal Treatment Failure and Current Concepts in Retreatment. J. Endod. 2006, 32, 93–98. [Google Scholar] [CrossRef]
- Jett, B.D.; Huycke, M.M.; Gilmore, M.S. Virulence of Enterococci. Clin. Microbiol. Rev. 1994, 7, 462–478. [Google Scholar] [CrossRef]
- Alghamdi, F.; Shakir, M. The Influence of Enterococcus Faecalis as a Dental Root Canal Pathogen on Endodontic Treatment: A Systematic Review. Cureus 2020, 12, e7257. [Google Scholar] [CrossRef] [PubMed] [Green Version]
- Bapat, R.A.; Joshi, C.P.; Bapat, P.; Chaubal, T.V.; Pandurangappa, R.; Jnanendrappa, N.; Gorain, B.; Khurana, S.; Kesharwani, P. The Use of Nanoparticles as Biomaterials in Dentistry. Drug Discov. Today 2019, 24, 85–98. [Google Scholar] [CrossRef] [PubMed]
- Yougbare, S.; Chang, T.-K.; Tan, S.-H.; Kuo, J.-C.; Hsu, P.-H.; Su, C.-Y.; Kuo, T.-R. Antimicrobial Gold Nanoclusters: Recent Developments and Future Perspectives. Int. J. Mol. Sci. 2019, 20, 2924. [Google Scholar] [CrossRef] [PubMed] [Green Version]
- Song, W.; Ge, S. Application of Antimicrobial Nanoparticles in Dentistry. Molecules 2019, 24, 1033. [Google Scholar] [CrossRef] [Green Version]
- Niño-Martínez, N.; Salas Orozco, M.F.; Martínez-Castañón, G.-A.; Torres Méndez, F.; Ruiz, F. Molecular Mechanisms of Bacterial Resistance to Metal and Metal Oxide Nanoparticles. Int. J. Mol. Sci. 2019, 20, 2808. [Google Scholar] [CrossRef] [PubMed] [Green Version]
- Duan, H.; Wang, D.; Li, Y. Green Chemistry for Nanoparticle Synthesis. Chem. Soc. Rev. 2015, 44, 5778–5792. [Google Scholar] [CrossRef]
- Loo, Y.Y.; Chieng, B.W.; Nishibuchi, M.; Radu, S. Synthesis of Silver Nanoparticles by Using Tea Leaf Extract from Camellia Sinensis. Int. J. Nanomed. 2012, 7, 4263–4267. [Google Scholar] [CrossRef] [Green Version]
- Committee for Clinical Laboratory Standards. Methods for Dilution Antimicrobial Susceptibility Tests for Bacteria That Grow Aerobically: M07-A10—Approved Standard, 10th ed.; Documents/Clinical and Laboratory Standards Institute: Wayne, PA, USA, 2015; ISBN 978-1-56238-987-1. [Google Scholar]
- Shankar, N.; Baghdayan, A.S.; Gilmore, M.S. Modulation of Virulence within a Pathogenicity Island in Vancomycin-Resistant Enterococcus Faecalis. Nature 2002, 417, 746–750. [Google Scholar] [CrossRef]
- Toledo-Arana, A.; Valle, J.; Solano, C.; Arrizubieta, M.J.; Cucarella, C.; Lamata, M.; Amorena, B.; Leiva, J.; Penades, J.R.; Lasa, I. The Enterococcal Surface Protein, Esp, Is Involved in Enterococcus Faecalis Biofilm Formation. Appl. Environ. Microbiol. 2001, 67, 4538–4545. [Google Scholar] [CrossRef] [Green Version]
- Mosselhy, D.A.; El-Aziz, M.A.; Hanna, M.; Ahmed, M.A.; Husien, M.M.; Feng, Q. Comparative Synthesis and Antimicrobial Action of Silver Nanoparticles and Silver Nitrate. J. Nanopart. Res. 2015, 17, 473. [Google Scholar] [CrossRef]
- Shah, M.R.; Ali, S.; Ateeq, M.; Perveen, S.; Ahmed, S.; Bertino, M.F.; Ali, M. Morphological Analysis of the Antimicrobial Action of Silver and Gold Nanoparticles Stabilized with Ceftriaxone on Escherichia Coli Using Atomic Force Microscopy. New J. Chem. 2014, 38, 5633–5640. [Google Scholar] [CrossRef]
- Ghasemi, F.; Jalal, R. Antimicrobial Action of Zinc Oxide Nanoparticles in Combination with Ciprofloxacin and Ceftazidime against Multidrug-Resistant Acinetobacter Baumannii. J. Glob. Antimicrob. Resist. 2016, 6, 118–122. [Google Scholar] [CrossRef] [PubMed]
- Samiei, M.; Farjami, A.; Dizaj, S.M.; Lotfipour, F. Nanoparticles for Antimicrobial Purposes in Endodontics: A Systematic Review of In Vitro Studies. Mater. Sci. Eng. C 2016, 58, 1269–1278. [Google Scholar] [CrossRef] [PubMed]
- Prabhu, S.; Poulose, E.K. Silver Nanoparticles: Mechanism of Antimicrobial Action, Synthesis, Medical Applications, and Toxicity Effects. Int. Nano Lett. 2012, 2, 32. [Google Scholar] [CrossRef] [Green Version]
- Mirhosseini, M.; Firouzabadi, F.B. Antibacterial Activity of Zinc Oxide Nanoparticle Suspensions on Food-Borne Pathogens. Int. J. Dairy Technol. 2013, 66, 291–295. [Google Scholar] [CrossRef]
- Mohammed, M.A.; Syeda, J.T.M.; Wasan, K.M.; Wasan, E.K. An Overview of Chitosan Nanoparticles and Its Application in Non-Parenteral Drug Delivery. Pharmaceutics 2017, 9, 53. [Google Scholar] [CrossRef] [Green Version]
- Kong, M.; Chen, X.G.; Xing, K.; Park, H.J. Antimicrobial Properties of Chitosan and Mode of Action: A State of the Art Review. Int. J. Food Microbiol. 2010, 144, 51–63. [Google Scholar] [CrossRef]
- Sirelkhatim, A.; Mahmud, S.; Seeni, A.; Kaus, N.H.M.; Ann, L.C.; Bakhori, S.K.M.; Hasan, H.; Mohamad, D. Review on Zinc Oxide Nanoparticles: Antibacterial Activity and Toxicity Mechanism. Nano-Micro Lett. 2015, 7, 219–242. [Google Scholar] [CrossRef] [Green Version]
- Arfat, Y.A.; Benjakul, S.; Prodpran, T.; Sumpavapol, P.; Songtipya, P. Properties and Antimicrobial Activity of Fish Protein Isolate/Fish Skin Gelatin Film Containing Basil Leaf Essential Oil and Zinc Oxide Nanoparticles. Food Hydrocoll. 2014, 41, 265–273. [Google Scholar] [CrossRef]
- Nair, N.; James, B.; Devadathan, A.; Johny, M.K.; Mathew, J.; Jacob, J. Comparative Evaluation of Antibiofilm Efficacy of Chitosan Nanoparticle- and Zinc Oxide Nanoparticle-Incorporated Calcium Hydroxide-Based Sealer: An In Vitro Study. Contemp. Clin. Dent. 2018, 9, 434–439. [Google Scholar] [CrossRef]
- Gillen, B.M.; Looney, S.W.; Gu, L.-S.; Loushine, B.A.; Weller, R.N.; Loushine, R.J.; Pashley, D.H.; Tay, F.R. Impact of the Quality of Coronal Restoration versus the Quality of Root Canal Fillings on Success of Root Canal Treatment: A Systematic Review and Meta-Analysis. J. Endod. 2011, 37, 895–902. [Google Scholar] [CrossRef] [PubMed] [Green Version]
- Alenazy, M.S.; Mosadomi, H.A.; Al-Nazhan, S.; Rayyan, M.R. Clinical Considerations of Nanobiomaterials in Endodontics: A Systematic Review. Saudi Endod. J. 2018, 8, 163. [Google Scholar] [CrossRef]
- Mah, T.-F.C.; O’Toole, G.A. Mechanisms of Biofilm Resistance to Antimicrobial Agents. Trends Microbiol. 2001, 9, 34–39. [Google Scholar] [CrossRef]
- Kayaoglu, G.; Ørstavik, D. Virulence Factors of Enterococcus Faecalis: Relationship to Endodontic Disease. Crit. Rev. Oral Biol. Med. 2004, 15, 308–320. [Google Scholar] [CrossRef] [PubMed] [Green Version]
- Iravani, S. Green Synthesis of Metal Nanoparticles Using Plants. Green Chem. 2011, 13, 2638. [Google Scholar] [CrossRef]
- Oikeh, E.I.; Omoregie, E.S.; Oviasogie, F.E.; Oriakhi, K. Phytochemical, Antimicrobial, and Antioxidant Activities of Different Citrus Juice Concentrates. Food Sci. Nutr. 2015, 4, 103–109. [Google Scholar] [CrossRef]
- Dhanavade, M.J.; Jalkute, C.B.; Ghosh, J.S.; Sonawane, K.D. Study Antimicrobial Activity of Lemon (Citrus Lemon L.) Peel Extract. Br. J. Pharmacol. Toxicol. 2011, 2, 119–122. [Google Scholar]
- Mavila, S.; Eivgi, O.; Berkovich, I.; Lemcoff, N.G. Intramolecular Cross-Linking Methodologies for the Synthesis of Polymer Nanoparticles. Chem. Rev. 2016, 116, 878–961. [Google Scholar] [CrossRef]
- Mousavi, S.A.; Ghotaslou, R.; Khorramdel, A.; Akbarzadeh, A.; Aeinfar, A. Antibacterial and Antifungal Impacts of Combined Silver, Zinc Oxide, and Chitosan Nanoparticles within Tissue Conditioners of Complete Dentures In Vitro. Ir. J. Med. Sci. 2020, 189, 1343–1350. [Google Scholar] [CrossRef]
- Beer, C.; Foldbjerg, R.; Hayashi, Y.; Sutherland, D.S.; Autrup, H. Toxicity of Silver Nanoparticles—Nanoparticle or Silver Ion? Toxicol. Lett. 2012, 208, 286–292. [Google Scholar] [CrossRef]
- Li, L.-H.; Deng, J.-C.; Deng, H.-R.; Liu, Z.-L.; Li, X.-L. Preparation, Characterization and Antimicrobial Activities of Chitosan/Ag/ZnO Blend Films. Chem. Eng. J. 2010, 1, 378–382. [Google Scholar] [CrossRef]
- Hernández-Sierra, J.F.; Ruiz, F.; Cruz Pena, D.C.; Martínez-Gutiérrez, F.; Martínez, A.E.; de Jesús Pozos Guillén, A.; Tapia-Pérez, H.; Castañón, G.M. The Antimicrobial Sensitivity of Streptococcus Mutans to Nanoparticles of Silver, Zinc Oxide, and Gold. Nanomed. Nanotechnol. Biol. Med. 2008, 4, 237–240. [Google Scholar] [CrossRef] [PubMed]
- Panpaliya, N.P.; Dahake, P.T.; Kale, Y.J.; Dadpe, M.V.; Kendre, S.B.; Siddiqi, A.G.; Maggavi, U.R. In Vitro Evaluation of Antimicrobial Property of Silver Nanoparticles and Chlorhexidine against Five Different Oral Pathogenic Bacteria. Saudi Dent. J. 2019, 31, 76–83. [Google Scholar] [CrossRef] [PubMed]
- Sevinç, B.A.; Hanley, L. Antibacterial Activity of Dental Composites Containing Zinc Oxide Nanoparticles. J. Biomed. Mater. Res. B Appl. Biomater. 2010, 94, 22–31. [Google Scholar] [CrossRef] [Green Version]
- Imazato, S.; Torii, M.; Tsuchitani, Y.; McCabe, J.F.; Russell, R.R.B. Incorporation of Bacterial Inhibitor into Resin Composite. J. Dent. Res. 1994, 73, 1437–1443. [Google Scholar] [CrossRef]
- Syafiuddin, T.; Hisamitsu, H.; Toko, T.; Igarashi, T.; Goto, N.; Fujishima, A.; Miyazaki, T. In Vitro Inhibition of Caries around a Resin Composite Restoration Containing Antibacterial Filler. Biomaterials 1997, 18, 1051–1057. [Google Scholar] [CrossRef]
- Andrade, V.; Martínez, A.; Rojas, N.; Bello-Toledo, H.; Flores, P.; Sánchez-Sanhueza, G.; Catalán, A. Antibacterial Activity against Streptococcus Mutans and Diametrical Tensile Strength of an Interim Cement Modified with Zinc Oxide Nanoparticles and Terpenes: An In Vitro Study. J. Prosthet. Dent. 2018, 119, 862.e1–862.e7. [Google Scholar] [CrossRef] [PubMed]
- Dutra-Correa, M.; Leite, A.A.B.V.; de Cara, S.P.H.M.; Diniz, I.M.A.; Marques, M.M.; Suffredini, I.B.; Fernandes, M.S.; Toma, S.H.; Araki, K.; Medeiros, I.S. Antibacterial Effects and Cytotoxicity of an Adhesive Containing Low Concentration of Silver Nanoparticles. J. Dent. 2018, 77, 66–71. [Google Scholar] [CrossRef]
- Rukholm, G.; Mugabe, C.; Azghani, A.; Omri, A. Antibacterial Activity of Liposomal Gentamicin against Pseudomonas Aeruginosa: A Time-Kill Study. Int. J. Antimicrob. Agents 2006, 27, 247–252. [Google Scholar] [CrossRef]
- Balouiri, M.; Sadiki, M.; Ibnsouda, S.K. Methods for In Vitro Evaluating Antimicrobial Activity: A Review. J. Pharm. Anal. 2016, 6, 71–79. [Google Scholar] [CrossRef] [PubMed] [Green Version]
- Theophel, K.; Schacht, V.J.; Schlater, M.; Schnell, S.; Stingu, C.-S.; Schaumann, R.; Bunge, M. The Importance of Growth Kinetic Analysis in Determining Bacterial Susceptibility against Antibiotics and Silver Nanoparticles. Front. Microbiol. 2014, 5, 544. [Google Scholar] [CrossRef] [PubMed]

| Zone of Inhibition against Enterococcus faecalis | |||||
|---|---|---|---|---|---|
| Sample | Zone of Inhibition (Concentration) in mm | ||||
| 25 µg/L | 50 µg/L | 75 µg/L | 100 µg/L | 150 µg/L | |
| Li-AgNP | 27 | 30 | 32 | 34 | 40 |
| Li-ZnNP | 12 | 14 | 23 | 25 | 29 |
| Li-CSNP | 14 | 18 | 25 | 26 | 32 |
| Li-Ag/Zn/CSNC | 23 | 24 | 28 | 30 | 42 |
| Time Intervals | Mean ± SD | Mean Ranks | Chi Square | p Value |
|---|---|---|---|---|
| 1 h | 0.987 ± 0. 006 | 2.00 | 12.00 | 0.017 * |
| 2 h | 1.211 ± 0.004 | 5.00 | ||
| 3 h | 1.623 ± 0.004 | 11.00 | ||
| 4 h | 1.606 ± 0.006 | 8.00 | ||
| 5 h | 1.646 ± 0.001 | 14.00 |
| Time Intervals | Mean Difference | Chi Square | p Value |
|---|---|---|---|
| 1 h vs. 2 h | −0.22367 | −0.775 | 0.439 |
| 1 h vs. 3 h | −0.63600 | −2.324 | 0.020 * |
| 1 h vs. 4 h | −0.61933 | −1.549 | 0.121 |
| 1 h vs. 5 h | −0.65900 | −3.098 | 0.002 * |
| 2 h vs. 3 h | −0.41233 | −1.549 | 0.121 |
| 2 h vs. 4 h | −0.39567 | −0.775 | 0.439 |
| 2 h vs. 5 h | −0.43533 | −2.324 | 0.020 * |
| 3 h vs. 4 h | 0.01667 | 0.775 | 0.439 |
| 3 h vs. 5 h | −0.02300 | −0.775 | 0.439 |
| 4 h vs. 5 h | −0.03967 | −1.549 | 0.121 |
Publisher’s Note: MDPI stays neutral with regard to jurisdictional claims in published maps and institutional affiliations. |
© 2022 by the authors. Licensee MDPI, Basel, Switzerland. This article is an open access article distributed under the terms and conditions of the Creative Commons Attribution (CC BY) license (https://creativecommons.org/licenses/by/4.0/).
Share and Cite
Jose, J.; Teja, K.V.; Janani, K.; Alam, M.K.; Khattak, O.; Salloum, M.G.; Magar, S.S.; Magar, S.P.; Rajeshkumar, S.; Palanivelu, A.; et al. Preparation of a Novel Nanocomposite and Its Antibacterial Effectiveness against Enterococcus faecalis—An In Vitro Evaluation. Polymers 2022, 14, 1499. https://doi.org/10.3390/polym14081499
Jose J, Teja KV, Janani K, Alam MK, Khattak O, Salloum MG, Magar SS, Magar SP, Rajeshkumar S, Palanivelu A, et al. Preparation of a Novel Nanocomposite and Its Antibacterial Effectiveness against Enterococcus faecalis—An In Vitro Evaluation. Polymers. 2022; 14(8):1499. https://doi.org/10.3390/polym14081499
Chicago/Turabian StyleJose, Jerry, Kavalipurapu Venkata Teja, Krishnamachari Janani, Mohammad Khursheed Alam, Osama Khattak, Mahmoud Gamal Salloum, Shilpa S. Magar, Shaliputra P. Magar, Shanmugam Rajeshkumar, Ajitha Palanivelu, and et al. 2022. "Preparation of a Novel Nanocomposite and Its Antibacterial Effectiveness against Enterococcus faecalis—An In Vitro Evaluation" Polymers 14, no. 8: 1499. https://doi.org/10.3390/polym14081499
APA StyleJose, J., Teja, K. V., Janani, K., Alam, M. K., Khattak, O., Salloum, M. G., Magar, S. S., Magar, S. P., Rajeshkumar, S., Palanivelu, A., Srivastava, K. C., & Shrivastava, D. (2022). Preparation of a Novel Nanocomposite and Its Antibacterial Effectiveness against Enterococcus faecalis—An In Vitro Evaluation. Polymers, 14(8), 1499. https://doi.org/10.3390/polym14081499

